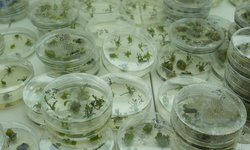
Kuraklığa Dayanıklı Domates Geliyor mu?

Siirt’te son dönemde yaşanan yoğun yağışlar, tarımsal üretimde verim beklentilerini yükseltti. Geçen yılın aynı dönemine göre yüzde 150’den fazla artış gösteren yağış, özellikle buğday, arpa ve mercimek üretiminde çiftçiye umut verdi.
Yağış Artışı Verimi Nasıl Etkiliyor?
Siirt İl Tarım ve Orman Müdürü Mustafa Şanverdi, ilin bereketli topraklarında güzel bir buğday sahasında olduklarını belirterek, “Geçen yıllarda yağış miktarının az olmasından sonra bu yıl gerçekleşen yağışlarla birlikte toprakları daha bereketli ve verimli görüyoruz. Yaklaşık 400 bin dönüm buğday ve arpa ekim alanımız var. Mercimekte de 130 bin dekar civarında ekim alanımız bulunuyor. Çiftçilerimizin ekim şekilleri ve taban gübresi kullanmalarıyla birlikte güzel bir hasat geçireceğimize dair umut var” dedi.
Yüzde 150’den Fazla Artış
Şanverdi, ekim ayından bu yana ölçülen yaklaşık 450 milimetre yağışın geçen yılın aynı dönemindeki 170 milimetreye kıyasla yüzde 150’den fazla artış sağladığını vurguladı. Bu durumun tarımsal hasılaya ve özellikle buğday, arpa ve mercimek verimine olumlu katkı sağlayacağını ifade etti.
Çiftçilere Saha Takibi ve Bilgilendirme
Tarım ve Orman İl Müdürlüğü olarak fenolojik gözlemlerin düzenli yapıldığını belirten Şanverdi, “İl müdürlüğü ve ilçelerdeki ekiplerimiz sürekli saha taramalarıyla buğday ve mercimek gelişimini takip ediyor ve ihtiyaç halinde çiftçilerimizi bilgilendiriyoruz. Önümüzdeki süreçte yağışlar istediğimiz gibi giderse çiftçilerimiz daha bereketli ve güzel bir ürün alacak” dedi.